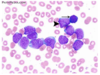
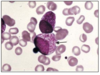

15. Leukaemia Flashcards
(18 cards)
What is leukaemia and what are the 4 types?
Why does cancer develop?
Describe the development of mature differentiated cells from a haematopoietic SC in the bone marrow.
Cancer of haemopoietic cells usually associated with increased numbers of WBC in the bone marrow or blood.
- Acute lymphoblastic leukaemia (ALL)
- Acute myeloid leukaemia (AML)
- Chronic myeloid leukaemia (CML)
- Chronic lymphocytic leukaemia (CLL)
Normal checks and balances in cell cycle regulation go awry -> cell divides and multiplies continuously.

Which part of the haematopoietic SC -> mature WBC process do the following malignancies occur?
a) ALL
b) CLL
c) Lymphoma
d) Myeloma
e) AML
f) Myeloproliferative disorders
CLL - cancer of B cells
Lymphoma incl. Hodkins and Non-Hodgkins. Swollen lymph node.

Where do the majority of blood cells come from in adults?
What are some laboratory tools for diagnosing haematological malignancies?
Sternum and hip bone (marrow).
Morphology: blood film, bone marrow biopsy
Immunophenotype: flow cytometry
Genetic and molecular features: chromosome abnormalities - G-banding and FISH, gene point mutations and insertions/deletions - PCR-based.
NB. Diagnoses can’t be made based on just morphology - immunophenotyping can help as diff proteins on cell surface
How does immunophenotyping work?
How does G-banding work?
How does FISH (fluorescence in situ hybridisation) work?
Buy abs (with fluorescent conjugate) which are targeted to specific things e.g. CD34 cell surface marker. Flow cytometer counts how many cells have CD34 on surface. Normally there’s a mix of all cells, so if results are almost all CD34 = problem!
Detects chromosomal abnormalities, cells cultured for short time, arrested at metaphase, chromosomes stained and laid out to be counted and checked for e.g. translocation. E.g. monosomy 7 = feature of ALL, process can take a week.
Uses fluorescent probes to detect specific DNA sequences. Can identify chromosomal translocations/gains/losses of regions in genome. Doesn’t need to be used with cells in metaphase, use if you know what you’re looking for e.g. translocation 15 -> 17 = type of ALL
What can sequencing technologies detect?
A 23 year old teacher visits her GP complaining of tiredness and gum bleeding. On examination she is pale, has swollen gums and lots of bruising and petechia (capillary haemorrhages under skin). Her blood tests showed Hb: 5g/dL, WCC 150, Plt 6. Her blood film is below.
What can you say about her blood results and the blood film?

Change in DNA sequences (mutations), which may affect protein function and contribute to cancer
Hb: low, normally 12.1 - 15.1
WCC: huge, normally 4-11
Plt: very low, should be 150 or above
Blood film: WBC abnormal, much bigger than RBC, massive nucelus. Small circles inside are nucleoli - only get them in blasts that are rapidly dividing. Explains high WCC and lack of normal cells.
What is ALL and AML characterised by in the lab? What does diagnosis require (cell number-wise)?
What are some signs/symptoms of bone marrow failure that might be apparent?
How is ALL/AML treated?
Accumulation of large numbers of undifferentiated cells (blasts) in bone marrow. A block in differentiation. Blasts rapidly overwhelm normal blood cells then spill into peripheral blood. Dx requires >20% blasts in bone marrow or blood.
Low Hb: anaemia, tiredness, SOB. If high WCC: leucostasis (viscous blood sticky/cloggy, problems with blood flow -> stroke, confusion). If low WCC: infections. Low platelets: bleeding and bruising.
Intensive, high dose, myelosupressive chemotherapy. Pts v. pancytopenic. Agressive, fast-growing and fatal if untreated.
What is AML?
How do people with AML present?
How is it diagnosed?
Malignant transformation of a myeloid precursor cell usually at a v early stage of myeloid development. More common in older people. Different genetic/molecular categories.
Bone marrow failure (Neutropenia: fever, pneumonia, fungal infection. Thrombocytopenia: bleeding. Anaemia), elevated WCC (blasts from bone marrow spilling into peripheral blood, causes leukostasis - stroke, headache, confused - and gum/skin infiltration), bone pain
Abnormal FBC (low Hb/low plts/high or low WCC), renal function, raised urate and LDH (markers of rapid cell turnover), clotting (APML, classically seen with abnormal clotting), blood film (below - see big blasts, big nuclei, thin cytoplasm ring nucleoli rapidly dividing), bone marrow biopsy, immunophenotyping (CD34), cytogenetics (lost part of chromosome 7), mutations (FTL3, MPML1).
What is the characteristic feature you would see in a blood film for AML and not ALL?
How are the symptoms of AML treated?
What is APML?
Auer rods - elongated structures (granule groups) (pic)
Anaemia - blood transfusion.
Thrombocytopenia - plt transfusion.
Neutropenia - prophylactic abx and fast sepsis treatment with broad spec abx e.g. ciprofloxacin, meropenem.
Tumor lysis (renal failure high K+, urate, phosphate, low Ca) - fluids, allopurinol/rasburicase.
Leucostasis - emg venesection/leucopharesis *remove some blood*
Subtype of AML, acute promyelocytic leukaemia, characteristic morphology of cells (hypergranular promyelocytes), present with abnormal clotting/severe bleeding or clots, t15:17, Tx: ATRA/arsenic, very treatable with great remission rates.
What are the 2 specialist treatments for acute leukemia?
What is a Hickman line?
What are the 2 different types of bone marrow transplant?
Intensive chemotherapy (usually daunorubicin and cytarabine - anti-metabolistes interfere with DNA synthesis, affects cells that have high turnover incl. leukaemia cells, hair, gut, bone marrow), allogenic SC transplant. Certain chromosome change varients of acute leukaemia have better survival rates. Good risk = 4 x intensive chemo. Medium/poor risk = chemo to remission then allogenic transplant.
Goes into superior vena cava, can stay in, useful b/d having so many drugs/blood products.
Autogenic: give own SCs. Allogenic: give someone else’s SCs.
Describe how an allogenic transplant occurs (2 types).
What is the survival rate?
_1. Myeloablation:_ wipe out BM completely. _2. Reduced intensity:_ make some room in BM for new SCs. Bone marrow (HLA antigens matched) harvest from donor's iliac crests, filtered, given to recipient. Donor cells grow, recognise any residual myeloleukaemic cells as foriegn and kill them = **graft vs. leukaemia effect**. Give **immunosuppression** too in case graft vs. host disease (attacks normal body cells).
Depends on risk group. 50% of kids and young adults = long term cure. <10% of pts >70yo.
What is ALL?
What are the signs and symptoms of ALL?
How is ALL diagnosed?
Malignant disease of undifferentiated lymphoblasts. Most common childhood cancer. And in elderly. 2 peaks - unlike AML where risk increases with age)
General (lethargy, bone pain, anorexia), bone marrow failure (Neutropenia: fever, pneumonia, fungal infection. Thrombocytopenia: bleeding. Anaemia), lymphadenopathy (particularly T-ALL) - mediastinal SVC obstruction, abdominal organomegaly, CNS involvement (5%)
Abnormal FBC (low Hb/low plts/high or low WCC), renal function/LFTs, blood film (pic), bone marrow biopsy, immunophenotyping (CD34+, TdT), cytogenetics, mutations.

Cytogenetics for ALL provides important diagnostic and prognostic information. What is common to see?
What are the 4 phases of ALL treatment?
What is the prognosis/response to treatment of ALL?
Hyperdiploid (51-65 chromosomes), t(9;22)(Philadelphia) (but this is more commonly associated with CML)
1. Remission induction: kill blast cells with combination of chemo drugs (vincristine, prednisolone, daunorubicin, asparaginase)
2. Consolidation: various combinations of chemotheraputic agents
3. CNS directed therapy: high dose systemic and intrathecal methotrexate to penetrate CNS and protect against CNS disease
4. Maintenance therapy: vincristine, prednisolone, mercaptopurine and methotrexate for 2-3 years
AML treatment simplier; ALL more complicated and lasts longer.
Child: >95% remission, >80% remain in remission. Adult: 80% remission, 20-40% remain in remission, may need allogenic bone marrow transplant
What are the chronic leukaemias, and how do they differ from the acute ones?
What is CLL?
What are the signs and symptoms of CLL?
CML, CLL, slower growing, don’t always require immediate treatment.
Proliferation of small mature B lymphocytes in the bone marrow and peripheral blood. Median age of presentation 65-70yrs. 80% diagnosed are asymptomatic.
Tiredness, night sweats, weight loss, symptoms related to anaemia, thrombocytopenia, lymphadenopathy, hepatosplenomegaly, recurrent infections due to immunosuppression (hypogammaglobulinaemia).
How is CLL diagnosed?
What would you see in a CLL blood film?
Is CLL always treated as soon as it’s diagnosed?
Lymphocytosis >5. Normochromic normocytic anaemia +/- autoimmune haemolytic anaemia. Thrombocytopenia. Hypogammaglobulinaemia. Diagnosis confirmed by immunophenotyping (surface proteins) and characteristic blood film (mature lymphocytosis with smear cells (very fragile, break)).
Lots of small mature lymphocytes with monomorphic appearance. Smear cells - artefact produced by a smear. (pic)
Use Binet classification criteria - if pt well, may only require observation.

CLL management: some patients may just need observation. What are the indications for treatment?
How is CLL treated?
What are some poor prognostic signs?
Progressive marrow failure, massive lymph node/organomegaly, systemic symptoms (tired, unwell), autoimmune cytopenias: haemolysis (AIHA - autoimmune haemolytic anaemia), platelets (ITP - autoimmune thrombocytopenia)
Combination chemothrapy (FCR: fludarabine, cyclophosphamide, rituximab). No benefit in treating early stage disease. Treat autoimmune complications with steroids. Supportive care: immunisations, transfusions etc.
Lymphocyte doubling time <12m, some chromosomal changes, mutations/deletions of tumor supressor gene TP53.
What is CML?
What would you see in a CML blood film?
How would someone with CML present?
What are the 3 phases of CML?
What translocation is characteristic of CML?
Disease of the SC in bone marrow.
Increased granulocytes - all stages of maturation, often plenty of eosinophils (pink-orange granules) and basophils (thick granules)(pic)
Weight loss, tired, night sweats, splenomegaly, anaemia. Increaesed number of neutrophils in blood.
Chronic (3-5y) -> accelerated (3-6m) -> blast crisis (3m) -> death
t(9;22) (Philadelphia chromosome)

How is CML treated?
What is MDS?
Imatinib - novel small molecule inhibitor of bcr-abl; highly tumor specific.
Myelodysplastic syndrome, type of cancer. Ineffective production of blood cells due to problem with haematopoietic SC in BM -> makes faulty red cells, neutrophils and platelets (myeloid lineage). Can develop severe anaemia, neutropenia, and thrombocytopenia. Usually in >65yr olds. Dx: blood film, BM biopsy, cytogenetics. Tx: transfusions, abx for infections, BM transplant. Prognosis depends on type/severity. May transform to AML.
What types of leukaemia are shown on these blood films A-F?

A: AML - auer rods
B: APML - subtype of AML, hypergranular promyelocytes
C: ALL
D: CLL - small mature lymphocytes with monomorphic appearance, smear cells
E, F: CML increased granulocytes at all stage of maturation - eosinophils (pink orange), basophils (thick)